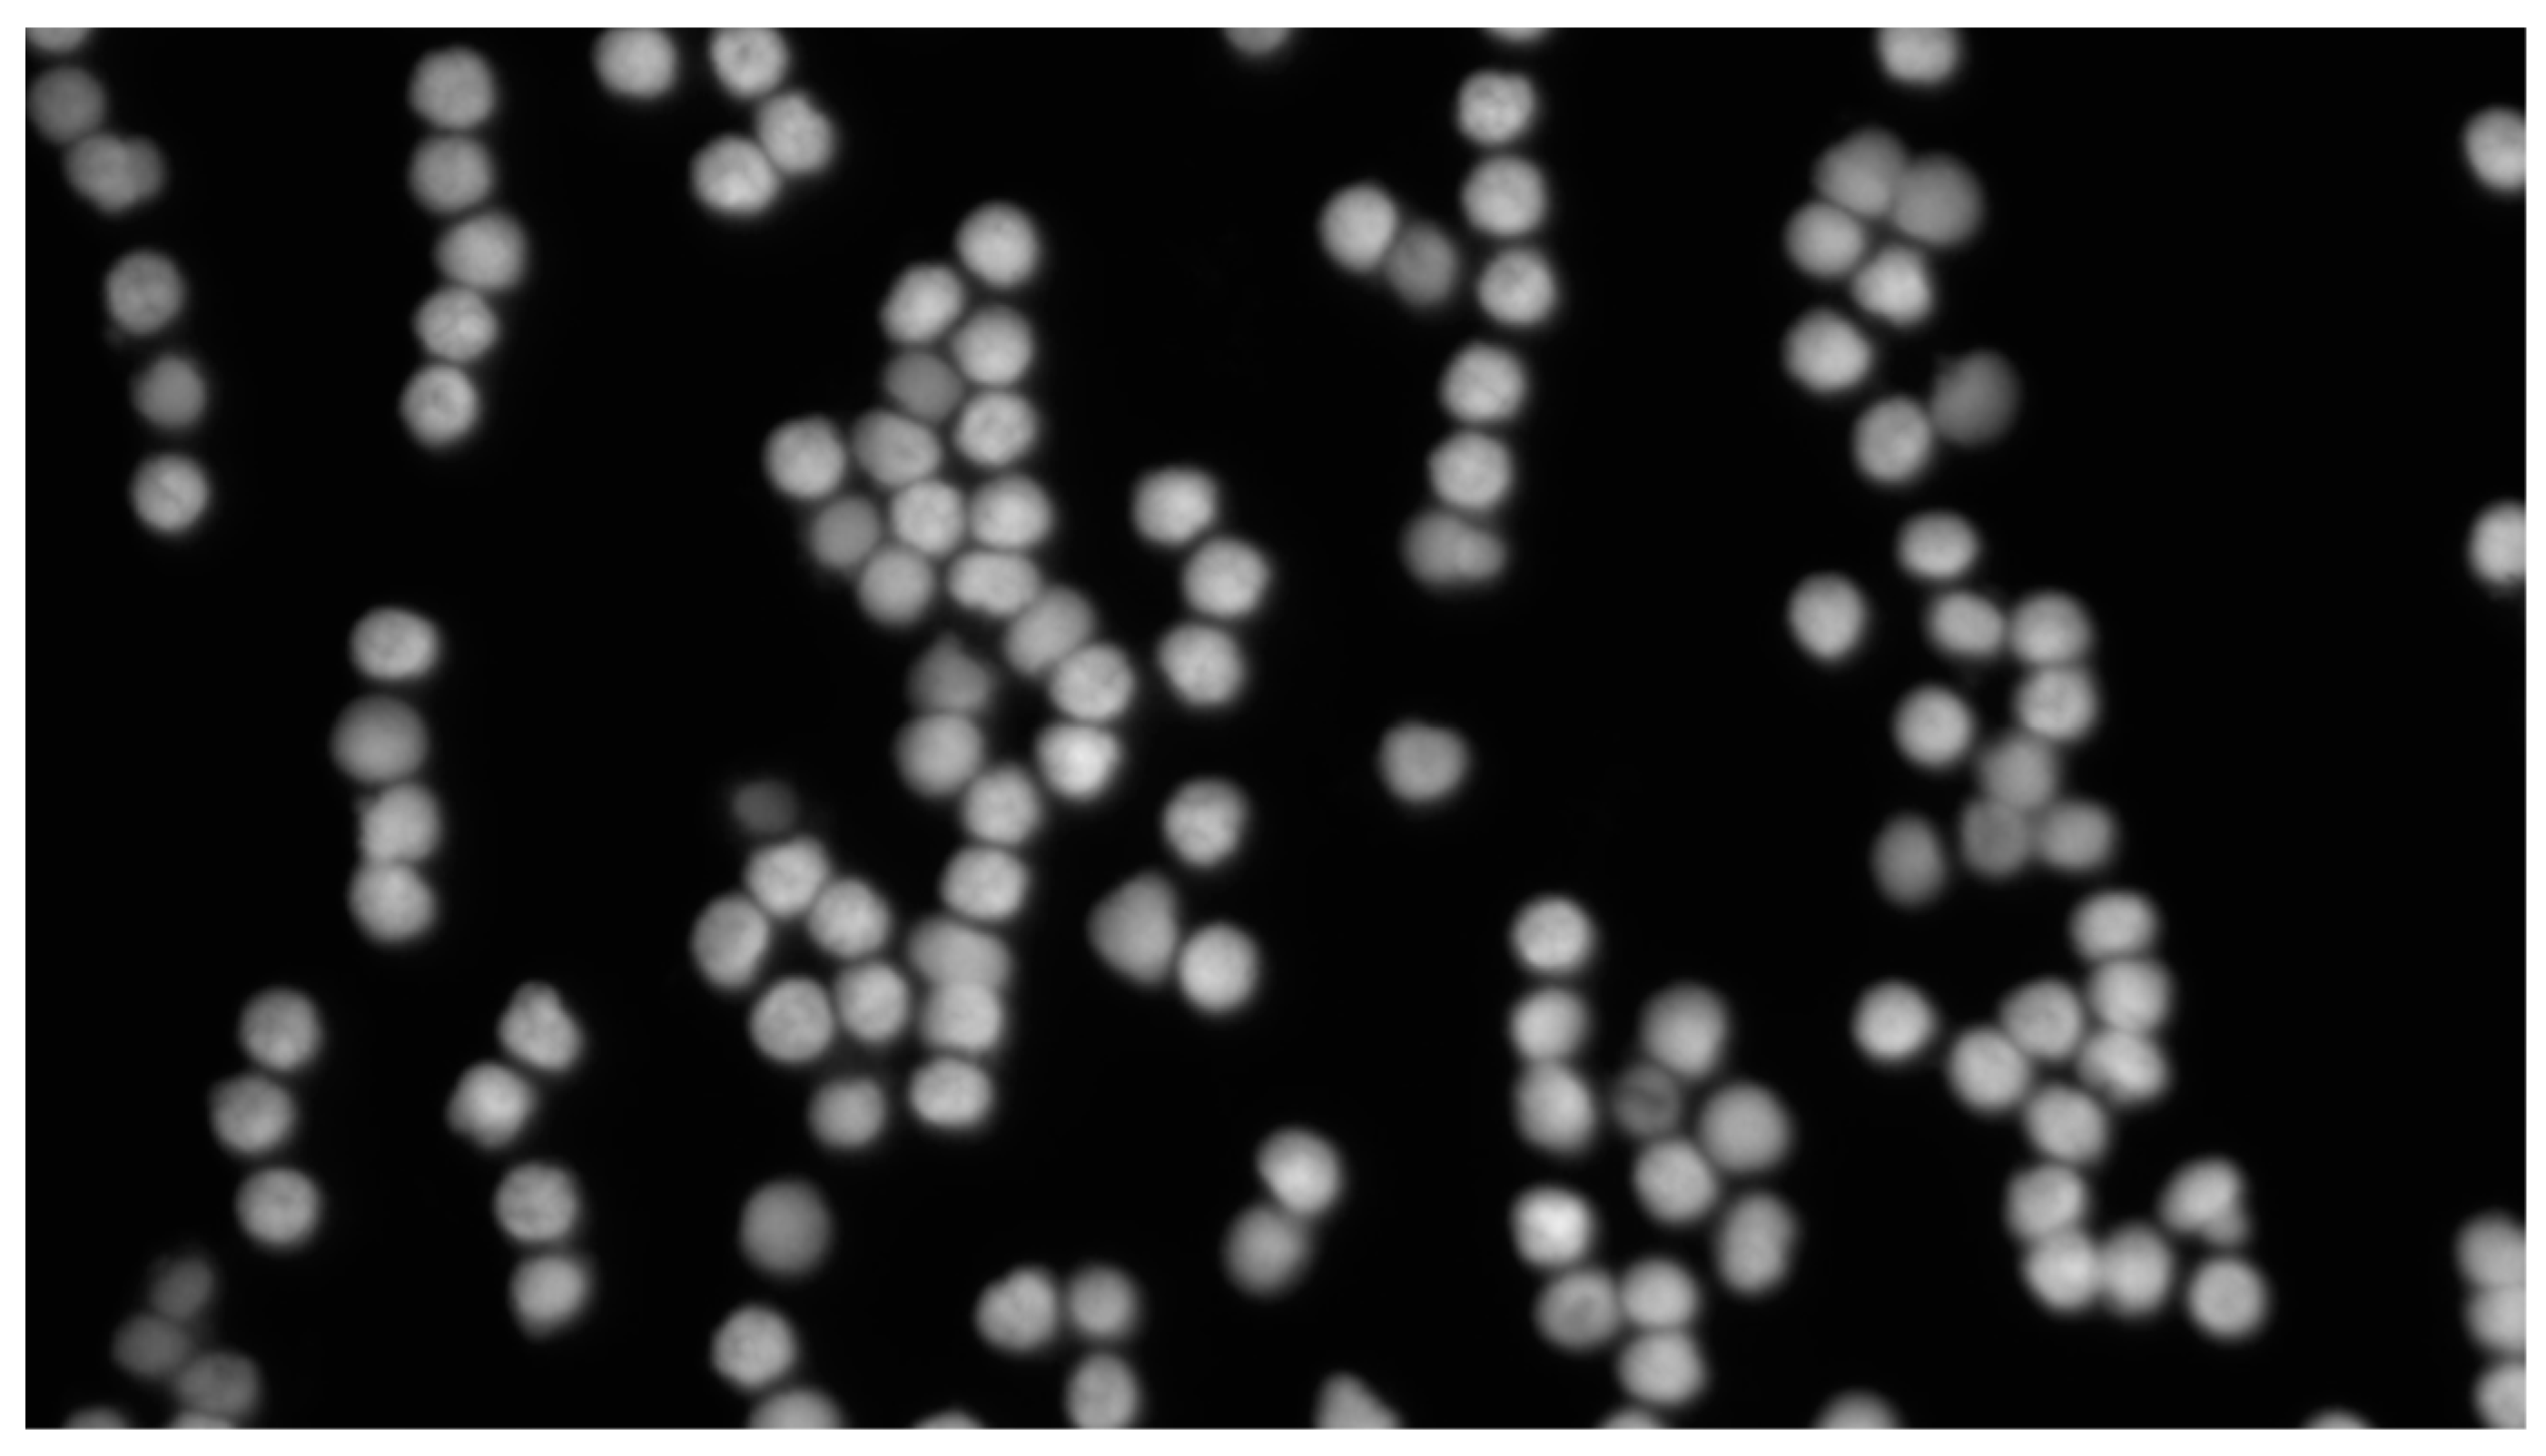
Sensors 24 00928 g001

An Improved Nested U-Net Network for Fluorescence In Situ Hybridization Cell Image Segmentation
Abstract
1. Introduction
- An improved network, SEAM-Unet++, based on the UNet++ network is proposed for cell contour segmentation in FISH images.
- Noting the weak cell boundaries, to further enhance the ability to extract valid features, we implement a convolutional block attention module (SEAM) in the UNet++ network to enhance the responsiveness of the output partially occluded contours and utilize depth-separable convolution to learn spatial dimensionality and channel correlation.
2. Materials
2.1. Image Acquisition
2.2. Image Preprocessing
3. Cells Segmentation Proposed Method
3.1. SEAM-Unet++ Network
3.2. Attention Mechanism
3.3. SEAM Attention Module
4. Evaluation Indexes
5. Experiments
5.1. Experimental Configuration and Hyperparameter Settings
5.2. Comparison of the Performance of the Models
6. Conclusions
Author Contributions
Funding
Institutional Review Board Statement
Informed Consent Statement
Data Availability Statement
Conflicts of Interest
References
- Hwang, C.C.; Pintye, M.; Chang, L.C.; Chen, H.-Y.; Yeh, K.-Y.; Chein, H.-P.; Lee, N.; Chen, J.-R. Dual-colour chromogenic in-situ hybridization is a potential alternative to fluorescence in-situ hybridization in HER2 testing. Histopathology 2011, 59, 984–992. [Google Scholar] [CrossRef]
- Jayasena Kaluarachchi, T.; Wickremasinghe, R.; Weerasekera, M.; Yasawardene, S.; McBain, A.J.; Yapa, B.; De Silva, H.; Menike, C.; Jayathilake, S.; Munasinghe, A.; et al. Diagnosing human cutaneous leishmaniasis using fluorescence in situ hybridization. Pathog. Glob. Health 2021, 115, 307–314. [Google Scholar] [CrossRef]
- Yang, R.; Jiang, M.; Zhao, J.; Chen, H.; Gong, J.; You, Y.; Song, L.; Li, Z.; Li, Q. Identification of chromosomal abnormalities and genomic features in near-triploidy/tetraploidy-acute leukemia by fluorescence in situ hybridization. Cancer Manag. Res. 2019, 11, 1559–1567. [Google Scholar] [CrossRef]
- Shirsat, H.S.; Epari, S.; Shet, T.; Bagal, R.; Hawaldar, R.; Desai, S.B. HER 2 status in invasive breast cancer: Immunohisto-chemistry, fluorescence in-situ hybridization and chromogenic in-situ hybridization. Indian J. Pathol. Microbiol. 2012, 55, 175. [Google Scholar]
- Gekas, J.; van den Berg, D.G.; Durand, A.; Vallée, M.; Wildschut, H.I.J.; Bujold, E.; Forest, J.-C.; Rousseau, F.; Reinharz, D. Rapid testing versus karyotyping in Down’s syndrome screening: Cost-effectiveness and detection of clinically significant chromosome abnormalities. Eur. J. Hum. Genet. 2011, 19, 3–9. [Google Scholar] [CrossRef]
- Yang, H.; Jo, E.; Kim, H.J.; Cha, I.; Jung, Y.; Nam, W.; Kim, J.-Y.; Kim, J.-K.; Kim, Y.H.; Oh, T.G.; et al. Deep learning for automated detection of cyst and tumors of the jaw in panoramic radiographs. J. Clin. Med. 2020, 9, 1839. [Google Scholar] [CrossRef]
- Jiang, X.; Xu, C. Deep learning and machine learning with grid search to predict later occurrence of breast Cancer metastasis using clinical data. J. Clin. Med. 2022, 11, 5772. [Google Scholar] [CrossRef]
- Kadomoto, S.; Uji, A.; Muraoka, Y.; Akagi, T.; Tsujikawa, A. Enhanced visualization of retinal microvasculature in optical coherence tomography angiography imaging via deep learning. J. Clin. Med. 2020, 9, 1322. [Google Scholar] [CrossRef]
- Xu, X.; Li, C.; Lan, X.; Fan, X.; Lv, X.; Ye, X.; Wu, T. A Lightweight and Robust Framework for Circulating Genetically Abnormal Cells (CACs) Identification Using 4-Color Fluorescence In Situ Hybridization (FISH) Image and Deep Refined Learning. J. Digit. Imaging 2023, 36, 1687–1700. [Google Scholar] [CrossRef] [PubMed]
- Xue, T.; Chang, H.; Ren, M.; Wang, H.; Yang, Y.; Wang, B.; Lv, L.; Tang, L.; Fu, C.; Qu, F.; et al. Deep learning to automatically evaluate HER2 gene amplification status from fluorescence in situ hybridization images. Sci. Rep. 2023, 13, 9746. [Google Scholar] [CrossRef] [PubMed]
- Zakrzewski, F.; de Back, W.; Weigert, M.; Wenke, T.; Zeugner, S.; Mantey, R.; Sperling, C.; Friedrich, K.; Roeder, I.; Aust, D.; et al. Automated detection of the HER2 gene amplification status in Fluorescence in situ hybridization images for the diagnostics of cancer tissues. Sci. Rep. 2019, 9, 8231. [Google Scholar] [CrossRef]
- Jumutc, V.; Bļizņuks, D.; Lihachev, A. Multi-Path U-Net architecture for cell and colony-forming unit image segmentation. Sensors 2022, 22, 990. [Google Scholar] [CrossRef]
- Rensink, R.A. The dynamic representation of scenes. Vis. Cogn. 2000, 7, 17–42. [Google Scholar] [CrossRef]
- Corbetta, M.; Shulman, G.L. Control of goal-directed and stimulus-driven attention in the brain. Nat. Rev. Neurosci. 2002, 3, 201–215. [Google Scholar] [CrossRef] [PubMed]
- Biswas, M.; Pramanik, R.; Sen, S.; Sinitca, A.; Kaplun, D.; Sarkar, R. Microstructural segmentation using a union of attention guided U-Net models with different color transformed images. Sci. Rep. 2023, 13, 5737. [Google Scholar] [CrossRef] [PubMed]
- Karthik, R.; Radhakrishnan, M.; Rajalakshmi, R.; Raymann, J. Delineation of ischemic lesion from brain MRI using attention gated fully convolutional network. Biomed. Eng. Lett. 2021, 11, 3–13. [Google Scholar] [CrossRef] [PubMed]
- Duan, J.; Zhang, X.; Shi, T. A hybrid attention-based paralleled deep learning model for tool wear prediction. Expert Syst. Appl. 2023, 211, 118548. [Google Scholar] [CrossRef]
- Guo, M.H.; Xu, T.X.; Liu, J.J.; Liu, Z.N.; Jiang, P.T.; Mu, T.J.; Zhang, S.H.; Martin, R.R.; Cheng, M.M.; Hu, S.M. Attention mechanisms in computer vision: A survey. Comput. Vis. Media 2022, 8, 331–368. [Google Scholar] [CrossRef]
- Mohr, J.; Park, J.H.; Obermayer, K. A computer vision system for rapid search inspired by surface-based attention mechanisms from human perception. Neural Netw. 2014, 60, 182–193. [Google Scholar] [CrossRef] [PubMed]
- Li, B.; Ye, L.; Liang, J.; Han, J. Region-of-interest and channel attention-based joint optimization of image compression and computer vision. Neurocomputing 2022, 500, 13–25. [Google Scholar] [CrossRef]
- Gao, H.; Xiao, J.; Yin, Y.; Liu, T.; Shi, J. A mutually supervised graph attention network for few-shot segmentation: The perspective of fully utilizing limited samples. IEEE Trans. Neural Netw. Learn. Syst. 2022, in press. [Google Scholar] [CrossRef]
- Wei, R.; Love, P.E.D.; Fang, W.; Luo, H.; Xu, S. Recognizing people’s identity in construction sites with computer vision: A spatial and temporal attention pooling network. Adv. Eng. Inform. 2019, 42, 100981. [Google Scholar] [CrossRef]
- Li, Y.; Zhao, J.; Lv, Z.; Pan, Z. Multimodal medical supervised image fusion method by CNN. Front. Neurosci. 2021, 15, 638976. [Google Scholar] [CrossRef]
- El-Shafai, W.; Mahmoud, A.; Ali, A.; El-Rabaie, E.; Taha, T.; Zahran, O.; El-Fishawy, A.; Soliman, N.; Alhussan, A.; Abd El-Samie, F.E. Deep cnn model for multimodal medical image denoising. Comput. Mater. Contin. 2022, 73, 3795–3814. [Google Scholar] [CrossRef]
- Salehi, A.W.; Khan, S.; Gupta, G.; Alabduallah, B.L.; Almjally, A.; Alsolai, H.; Siddiqui, T.; Mellit, A. A Study of CNN and Transfer Learning in Medical Imaging: Advantages, Challenges, Future Scope. Sustainability 2023, 15, 5930. [Google Scholar] [CrossRef]
- Ronneberger, O.; Fischer, P.; Brox, T. U-net: Convolutional networks for biomedical image segmentation. In Proceedings of the Medical Image Computing and Computer-Assisted Intervention–MICCAI 2015, 18th International Conference, Munich, Germany, 5–9 October 2015; pp. 234–241. [Google Scholar]
- Zhou, Z.; Rahman Siddiquee, M.M.; Tajbakhsh, N.; Liang, J. Unet++: A nested u-net architecture for medical image segmentation. In Proceedings of the Deep Learning in Medical Image Analysis and Multimodal Learning for Clinical Decision Support: 4th International Workshop, DLMIA 2018, and 8th International Workshop, ML-CDS 2018, Held in Conjunction with MICCAI 2018, Granada, Spain, 20 September 2018; pp. 3–11. [Google Scholar]
- Shen, J.; Li, T.; Hu, C.; He, H.; Liu, J. Automatic cell segmentation using mini-u-net on fluorescence in situ hybridization images. Proc. SPIE 2019, 10950, 109502T. [Google Scholar]
- Shen, J.; Li, T.; Hu, C.; He, H.; Jiang, D.; Liu, J. An Augmented Cell Segmentation in Fluorescent in Situ Hybridization Images. In Proceedings of the 2019 41st Annual International Conference of the IEEE Engineering in Medicine and Biology Society (EMBC), Berlin, Germany, 23–27 July 2019; pp. 6306–6309. [Google Scholar]
- Li, D.; Tang, P.; Zhang, R.; Sun, C.; Li, Y.; Qian, J.; Liang, Y.; Yang, J.; Zhang, L. Robust blood cell image segmentation method based on neural ordinary differential equations. Comput. Math. Methods Med. 2021, 2021, 5590180. [Google Scholar] [CrossRef]
- Thi Le, P.; Pham, T.; Hsu, Y.C.; Wang, J. Convolutional blur attention network for cell nuclei segmentation. Sensors 2022, 22, 1586. [Google Scholar] [CrossRef] [PubMed]
- Shen, D.; Wu, G.; Suk, H.I. Deep learning in medical image analysis. Annu. Rev. Biomed. Eng. 2017, 19, 221–248. [Google Scholar] [CrossRef] [PubMed]
- Cheng, J.Z.; Ni, D.; Chou, Y.H.; Qin, J.; Tiu, C.M.; Chang, Y.C.; Huang, C.S.; Shen, D.; Chen, C.M. Computer-aided diagnosis with deep learning architecture: Applications to breast lesions in US images and pulmonary nodules in CT scans. Sci. Rep. 2016, 6, 24454. [Google Scholar] [CrossRef] [PubMed]
- Shen, W.; Zhou, M.; Yang, F.; Yang, C.; Tian, J. Multi-scale convolutional neural networks for lung nodule classification. In Proceedings of the Information Processing in Medical Imaging: 24th International Conference, IPMI 2015, Sabhal Mor Ostaig, Isle of Skye, UK, 28 June–3 July 2015; pp. 588–599. [Google Scholar]
- Roth, H.R.; Lu, L.; Liu, J.; Yao, J.; Seff, A.; Cherry, K.; Kim, L.; Summers, R. Improving computer-aided detection using convolutional neural networks and random view aggregation. IEEE Trans. Med. Imaging 2016, 35, 1170–1181. [Google Scholar] [CrossRef]
- Ciompi, F.; de Hoop, B.; van Riel, S.J.; Chung, K.; Scholten, E.T.; Oudkerk, M.; Pim, A.d.J.; Prokop, M.; Ginneken, B.V. Automatic classification of pulmonary perifissural nodules in computed tomography using an ensemble of 2D views and a convolutional neural network out-of-the-box. Med. Image Anal. 2015, 26, 195–202. [Google Scholar] [CrossRef] [PubMed]
- Yu, X.; Wang, J.; Hong, Q.Q.; Teku, R.; Wang, S.H.; Zhang, T.D. Transfer learning for medical images analyses: A survey. Neurocomputing 2022, 489, 230–254. [Google Scholar] [CrossRef]
- Niu, S.; Liu, M.; Liu, Y.; Wang, J.; Song, H. Distant domain transfer learning for medical imaging. IEEE J. Biomed. Health Inform. 2021, 25, 3784–3793. [Google Scholar] [CrossRef]
- Hua, J.; Zeng, L.; Li, G.; Ju, Z. Learning for a robot: Deep reinforcement learning, imitation learning, transfer learning. Sensors 2021, 21, 1278. [Google Scholar] [CrossRef] [PubMed]
- Mougeot, G.; Dubos, T.; Chausse, F.; Péry, E.; Graumann, K.; Tatout, C.; Evans, D.E.; Desset, S. Deep learning—Promises for 3D nuclear imaging: A guide for biologists. J. Cell Sci. 2022, 135, jcs258986. [Google Scholar] [CrossRef]
- Li, H.; Wang, L.; Cheng, S. HARNU-Net: Hierarchical Attention Residual Nested U-Net for Change Detection in Remote Sensing Images. Sensors 2022, 22, 4626. [Google Scholar] [CrossRef]
- Liu, B.; Yu, A.; Gao, K.; Wang, Y.; Yu, X.; Zhang, P. Multiscale nested U-Net for small sample classification of hyperspectral images. J. Appl. Remote Sens. 2022, 16, 016506. [Google Scholar] [CrossRef]
- Kundu, S.; Karale, V.; Ghorai, G.; Sarkar, G.; Ghosh, S.; Dhara, A. Nested U-Net for segmentation of red lesions in retinal fundus images and sub-image classification for removal of false positives. J. Digit. Imaging 2022, 35, 1111–1119. [Google Scholar] [CrossRef]
- Li, C.; Tan, Y.; Chen, W.; Luo, X.; He, Y.; Gao, Y.; Li, F. ANU-Net: Attention-based nested U-Net to exploit full resolution features for medical image segmentation. Comput. Graph. 2020, 90, 11–20. [Google Scholar] [CrossRef]
- Yu, Z.; Huang, H.; Chen, W.; Su, Y.; Liu, Y.; Wang, X. Yolo-facev2: A scale and occlusion aware face detector. arXiv 2022, arXiv:2208.02019. [Google Scholar]
- Wang, J.; Lei, Y.; Yang, X.; Zhang, F. A refinement network embedded with attention mechanism for computer vision based post-earthquake inspections of railway viaduct. Eng. Struct. 2023, 279, 115572. [Google Scholar] [CrossRef]
- Wu, G.; Zheng, W.S.; Lu, Y.; Tian, Q. PSLT: A Light-weight Vision Transformer with Ladder Self-Attention and Progressive Shift. IEEE Trans. Pattern Anal. Mach. Intell. 2023, 45, 11120–11135. [Google Scholar] [CrossRef] [PubMed]
- Liu, J.; Fan, X.; Jiang, J.; Liu, R.; Luo, Z. Learning a deep multi-scale feature ensemble and an edge-attention guidance for image fusion. IEEE Trans. Circuits Syst. Video Technol. 2021, 32, 105–119. [Google Scholar] [CrossRef]
- Li, C.; Li, S.; Wang, H.; Gu, F.; Ball, A. Attention-based deep meta-transfer learning for few-shot fine-grained fault diagnosis. Knowl.-Based Syst. 2023, 264, 110345. [Google Scholar] [CrossRef]
- Xiong, S.; Tan, Y.; Li, Y.; Wen, C.; Yan, P. Subtask attention based object detection in remote sensing images. Remote Sens. 2021, 13, 1925. [Google Scholar] [CrossRef]
- Ren, Y.; Yu, L.; Tian, S.; Cheng, J.; Guo, Z.; Zhang, Y. Serial attention network for skin lesion segmentation. J. Ambient. Intell. Humaniz. Comput. 2022, 13, 799–810. [Google Scholar] [CrossRef]
- Paoletti, M.E.; Tao, X.; Han, L.; Wu, Z.; Moreno-Álvarez, S.; Roy, S.K.; Plaza, A.; Haut, J. Parameter-free attention network for spectral-spatial hyperspectral image classification. IEEE Trans. Geosci. Remote Sens. 2023, 61, 5516817. [Google Scholar] [CrossRef]
- Wu, H.; He, F.; Si, T.; Duan, Y.; Yan, X. HIGSA: Human image generation with self-attention. Adv. Eng. Inform. 2023, 55, 101856. [Google Scholar] [CrossRef]
- Liu, M.; Wang, K.; Ji, R.; Ge, S.S.; Chen, J. Person image generation with attention-based injection net-work. Neurocomputing 2021, 460, 345–359. [Google Scholar] [CrossRef]
- Kar, A.; Petit, M.; Refahi, Y.; Cerutti, G.; Godin, C.; Traas, J. Benchmarking of deep learning algorithms for 3D instance segmentation of confocal image datasets. PLOS Comput. Biol. 2022, 18, e1009879. [Google Scholar] [CrossRef] [PubMed]
- Kumar, V.; Krolewski, D.M.; Hebda-Bauer, E.K.; Parsegian, A.; Martin, B.; Foltz, M.; Akil, H.; Watson, S. Optimization and evaluation of fluorescence in situ hybridization chain reaction in cleared fresh-frozen brain tissues. Brain Struct. Funct. 2021, 226, 481–499. [Google Scholar] [CrossRef] [PubMed]
- Lan, K.; Cheng, J.; Jiang, J.; Jiang, X.; Zhang, Q. Modified UNet++ with atrous spatial pyramid pooling for blood cell image segmentation. Math. Biosci. Eng. MBE 2023, 20, 1420–1433. [Google Scholar] [CrossRef] [PubMed]

| Label | Predict | Confusion Matrix |
|---|---|---|
| Positive | Positive | TP |
| Positive | Negative | FN |
| Negative | Positive | FP |
| Negative | Negative | TP |
| Name | Parameter |
|---|---|
| CPU | Intel Xeon Gold 5318Y |
| GPU | NVIDIA A100 |
| Programming language | Python 3.8.17 |
| Deep learning framework | Pytorch 1.8.0 |
| Model | Accuracy | Loss | IoU | Recall | Precision | Dice |
|---|---|---|---|---|---|---|
| SEAM-Unet++ | 0.9153 | 0.1037 | 0.9101 | 0.8977 | 0.8800 | 0.9432 |
| Unet++ | 0.9149 | 0.1163 | 0.9003 | 0.8958 | 0.8856 | 0.9435 |
| Unet | 0.9146 | 0.1071 | 0.9078 | 0.8935 | 0.8805 | 0.9442 |
| Kun Lan’s | 0.9148 | 0.1095 | 0.9053 | 0.8937 | 0.8829 | 0.9432 |
| DeepLab | 0.8851 | 0.2043 | 0.8270 | 0.8847 | 0.8185 | 0.8960 |
| PSPNet | 0.8533 | 0.1095 | 0.9053 | 0.8937 | 0.8829 | 0.9432 |
Disclaimer/Publisher’s Note: The statements, opinions and data contained in all publications are solely those of the individual author(s) and contributor(s) and not of MDPI and/or the editor(s). MDPI and/or the editor(s) disclaim responsibility for any injury to people or property resulting from any ideas, methods, instructions or products referred to in the content. |
© 2024 by the authors. Licensee MDPI, Basel, Switzerland. This article is an open access article distributed under the terms and conditions of the Creative Commons Attribution (CC BY) license (https://creativecommons.org/licenses/by/4.0/).
Share and Cite
Jian, Z.; Song, T.; Zhang, Z.; Ai, Z.; Zhao, H.; Tang, M.; Liu, K. An Improved Nested U-Net Network for Fluorescence In Situ Hybridization Cell Image Segmentation. Sensors 2024, 24, 928. https://doi.org/10.3390/s24030928
Jian Z, Song T, Zhang Z, Ai Z, Zhao H, Tang M, Liu K. An Improved Nested U-Net Network for Fluorescence In Situ Hybridization Cell Image Segmentation. Sensors. 2024; 24(3):928. https://doi.org/10.3390/s24030928
Chicago/Turabian StyleJian, Zini, Tianxiang Song, Zhihui Zhang, Zhao Ai, Heng Zhao, Man Tang, and Kan Liu. 2024. "An Improved Nested U-Net Network for Fluorescence In Situ Hybridization Cell Image Segmentation" Sensors 24, no. 3: 928. https://doi.org/10.3390/s24030928
APA StyleJian, Z., Song, T., Zhang, Z., Ai, Z., Zhao, H., Tang, M., & Liu, K. (2024). An Improved Nested U-Net Network for Fluorescence In Situ Hybridization Cell Image Segmentation. Sensors, 24(3), 928. https://doi.org/10.3390/s24030928
